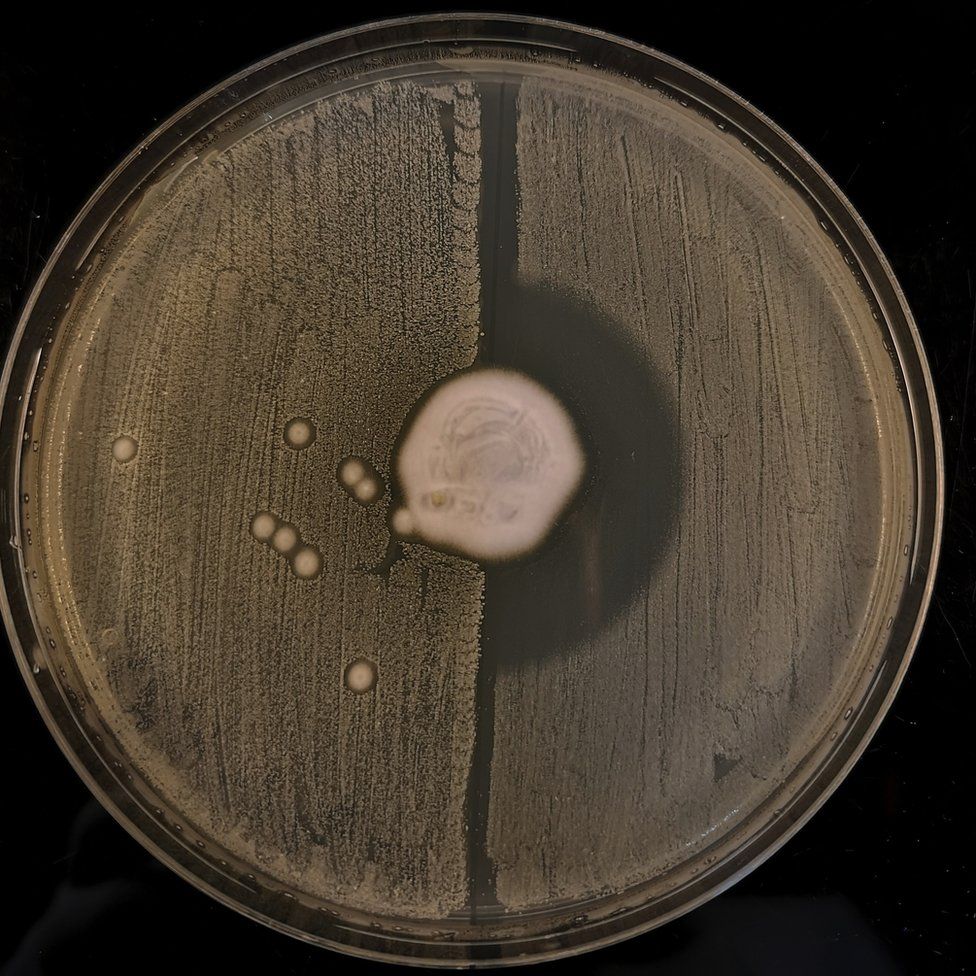
拼盘配图

研究:真菌细菌斗争进化 刺猬200年前 携耐药细菌



(剑桥7日综合电)野生刺猬皮肤上的真菌和细菌之间的斗争自然进化出一种耐抗生素的超级细菌,是一种抗耐甲氧西林黄金葡萄球菌(Methicillin-Resistant Staphylococcus Aureus,简称MRSA)。
在我们所熟悉的抗生素被发现之前,这种从刺猬身上衍生出来的细菌早已在自然界中发展起来。
ADVERTISEMENT
一个国际研究小组发现,刺猬体内常见的一种皮肤真菌会自然产生抗生素,其皮肤上的细菌因此产生了抗生素抗性。
首次在奶牛发现MecC-MRSA
研究人员说,他们发表在《自然》杂志上的研究结果表明,这种被称为MecC-MRSA的特殊细菌首次在奶牛身上被发现,人们当时认为是在奶牛场使用抗生素导致了抗药性的产生。
来自剑桥大学的首席研究人员之一霍姆斯教授告诉英国广播公司(BBC),这一发现“与人类在医疗环境中过度使用抗生素相比,只代表了很小部分的风险。”
大约每200个MRSA患者就有一个是受MecC-MRSA感染。在人类和农场动物身上过度使用抗生素,导致其他耐药性致病菌株继续出现。
剑桥大学的兽医科学家在10年前就发现了这种MRSA,而这项研究终于揭开了关于这种特殊类型的MRSA来源之谜。
霍姆斯教授解释说:“我们观察了野生动物和农场动物的情况,发现它在自然界中的分布显然非常广泛。当我们特别关注刺猬时,所取样的动物中有大约一半都携带这种类型的MRSA。”
耐药菌株19世纪初就出现
丹麦哥本哈根国立血清研究所的研究人员钻研从欧洲各地野生动物身上采集的1000多份细菌样本。他们建立了一个基于遗传密码的时间线,表明耐药菌株早在19世纪初就出现在欧洲的刺猬身上——远早于抗生素的临床使用。
霍姆斯教授解释:“生长在刺猬身上的真菌正释放青霉素,细菌如果想要在有真菌的刺猬身上生活,必须对其产生的抗生素有抵抗力。”
弗莱明在1928年注意到他培养皿中的凝胶被霉菌污染了,但霉菌附近没有细菌滋长,从而发现了青霉素。刺猬皮肤上的进化“军备竞赛”就是这一发现的一个例子。
这些科学家正在进行一项研究,旨在了解抗生素耐药菌的“库房”在哪里、它们是如何出现的,以及哪些做法和来源会对人们构成最大的风险。
霍姆斯教授说:“令人欣慰的是,我们有理由相信,出现在人们身上的这种MRSA类型不是因为奶牛场过度使用抗生素而导致的,但这并不意味着我们应该放松对抗生素使用的规定。”
他补充:“不仅仅是刺猬藏有耐抗生素细菌——所有野生动物都携带许多不同类型的细菌,还有寄生虫、真菌和病毒。”
ADVERTISEMENT
热门新闻
百格视频
ADVERTISEMENT
